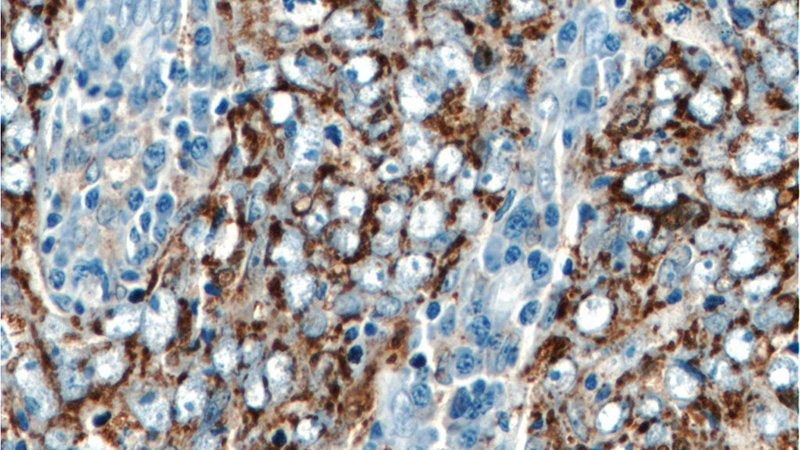
Immunohistochemistry of paraffin-embedded human breast cancer tissue slide using Catalog No:115493(SOD2 Antibody) at dilution of 1:50 (under 40x lens)

-
Product Name
SOD2 antibody
- Documents
-
Description
SOD2 Rabbit Polyclonal antibody. Positive IF detected in HUVEC cells. Positive IHC detected in human breast cancer tissue, human brain tissue, human small intestine tissue. Positive WB detected in HeLa cells, DU 145 cells, MCF7 cells, mouse brain tissue, rat brain tissue. Positive IP detected in mouse brain tissue. Observed molecular weight by Western-blot: 25 kDa
-
Tested applications
ELISA, WB, IF, IHC, IP
-
Species reactivity
Human, Mouse, Rat; other species not tested.
-
Alternative names
IPO B antibody; Mn SOD antibody; MNSOD antibody; SOD2 antibody; SODM antibody
-
Isotype
Rabbit IgG
-
Preparation
This antibody was obtained by immunization of SOD2 recombinant protein (Accession Number: NM_001322816). Purification method: Antigen Affinity purified.
-
Clonality
Polyclonal
-
Formulation
PBS with 0.02% sodium azide and 50% glycerol pH 7.3.
-
Storage instructions
Store at -20℃. DO NOT ALIQUOT
-
Applications
Recommended Dilution:
WB: 1:500-1:5000
IP: 1:500-1:5000
IHC: 1:20-1:200
IF: 1:20-1:200
-
Validations

HeLa cells were subjected to SDS PAGE followed by western blot with Catalog No:115493(SOD2 antibody) at dilution of 1:1000

IP Result of anti-SOD2 (IP:Catalog No:115493, 4ug; Detection:Catalog No:115493 1:1000) with mouse brain tissue lysate 4000ug.

Immunohistochemistry of paraffin-embedded human breast cancer tissue slide using Catalog No:115493(SOD2 Antibody) at dilution of 1:50 (under 10x lens)
Immunohistochemistry of paraffin-embedded human breast cancer tissue slide using Catalog No:115493(SOD2 Antibody) at dilution of 1:50 (under 40x lens)

Immunofluorescent analysis of HUVEC cells using Catalog No:115493(SOD2 Antibody) at dilution of 1:50 and Rhodamine-Goat anti-Rabbit IgG
-
Background
SOD2(superoxide dismutase 2, mitochondrial ) is also named as IPOB, MNSOD, SODM, Mn-SOD and belongs to the iron/manganese superoxide dismutase family. It is a marker of mitochondria, which is restricted to the perinuclear area in a cell with aggregate formation of mutant SOD1(PMID:12659845). It functions as the first line of antioxidant defense against highly reactive superoxide radicals and it appears to be early predictors for survival in septic patients with with MIF(PMID:20863520). It has 2 isoforms with the molecular weight of 25 kDa and 21 kDa.
-
References
- Zhao H, Wang R, Tao Z. Activation of T-LAK-cell-originated protein kinase-mediated antioxidation protects against focal cerebral ischemia-reperfusion injury. The FEBS journal. 281(19):4411-20. 2014.
- Aras S, Bai M, Lee I, Springett R, Hüttemann M, Grossman LI. MNRR1 (formerly CHCHD2) is a bi-organellar regulator of mitochondrial metabolism. Mitochondrion. 20:43-51. 2015.
- Dong D, Qi Y, Xu L. Total saponins from Rosa laevigata Michx fruit attenuates hepatic steatosis induced by high-fat diet in rats. Food & function. 5(12):3065-75. 2014.
- Dong D, Yin L, Qi Y, Xu L, Peng J. Protective Effect of the Total Saponins from Rosa laevigata Michx Fruit against Carbon Tetrachloride-Induced Liver Fibrosis in Rats. Nutrients. 7(6):4829-50. 2015.
- Liu M, Xu L, Yin L. Potent effects of dioscin against obesity in mice. Scientific reports. 5:7973. 2015.
- Zhang X, Han X, Yin L. Potent effects of dioscin against liver fibrosis. Scientific reports. 5:9713. 2015.
Related Products / Services
Please note: All products are "FOR RESEARCH USE ONLY AND ARE NOT INTENDED FOR DIAGNOSTIC OR THERAPEUTIC USE"
